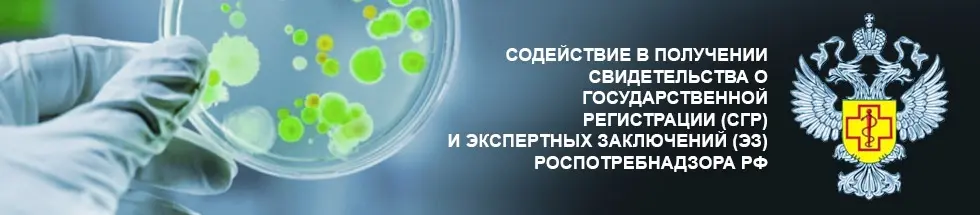

Менеджер по продажам в Смоленске
Заработная плата: от 40 000 рублей.
Занятость: полный рабочий день.
Условия:
- заработная плата = оклад +%+бонусные программы;
- отсутствие потолка заработной платы;
- возможность обучения и карьерного роста;
- работа в динамично развивающейся компании с молодым дружным коллективом;
- график работы 5/2 с 09.00 до 18.00;
- оформление по ТК.
Обязанности:
- активные продажи услуг по сертификации продукции:
- поиск‚ привлечение клиентов;
- ведение переговоров;
- заключение договоров;
- выполнение поставленных планов;
- отслеживание дебиторской задолженности;
- отчетность по формам руководства.
Требования:
- законченное образование (среднее профессиональное‚ высшее);
- успешный опыт активных продаж от 1 года (возможно — без опыта — обсуждается с конкретным кандидатом);
- навыки ведения переговоров;
- развитые коммуникативные навыки;
- грамотная речь;
- творческий подход к работе;
- владение ПК на уровне уверенного пользователя (MS Office‚ 1С).
Свое резюме вы можете отправить на электронную почту info-centr-es@mail.ru.
Мы аккредитованы
Наши Партнеры
+7 (499) 703-32-81
+7 (717) 276-05-54